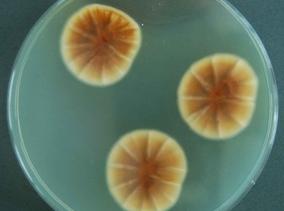

You are here
Home » All Fungi » Fungi » Ascomycota » Eurotiales » Aspergillaceae » Aspergillus » Aspergillus versicolor -
All Fungi
Aspergillus versicolor
Nomenclature
-
Family: AspergillaceaeGenus: Aspergillus
Species:
Aspergillus versicolor